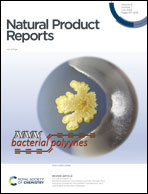

Gold-catalyzed cyclization and cycloaddition in natural product synthesis
Abstract
Covering: 2016 to mid 2023
Transition metal catalysis, known for its remarkable capacity to expedite the assembly of molecular complexity from readily available starting materials in a single operation, occupies a central position in contemporary chemical synthesis. Within this landscape, gold-catalyzed reactions present a novel and versatile paradigm, offering robust frameworks for accessing diverse structural motifs. In this review, we highlighted a curated selection of publications in the past 8 years, focusing on the deployment of homogeneous gold catalysis in the ring-forming step for the total synthesis of natural products. These investigations are categorized based on the specific ring formations they engender, accentuating the prevailing gold-catalyzed methodologies applied to surmount intricate challenges in natural products synthesis.

- This article is part of the themed collections: Bridging excellence —20 years of CCS-RSC collaboration and the Young Chemist Award and The Synergy of Synthetic Methods Development and Natural Product Synthesis

Please wait while we load your content...
Please wait while we load your content...